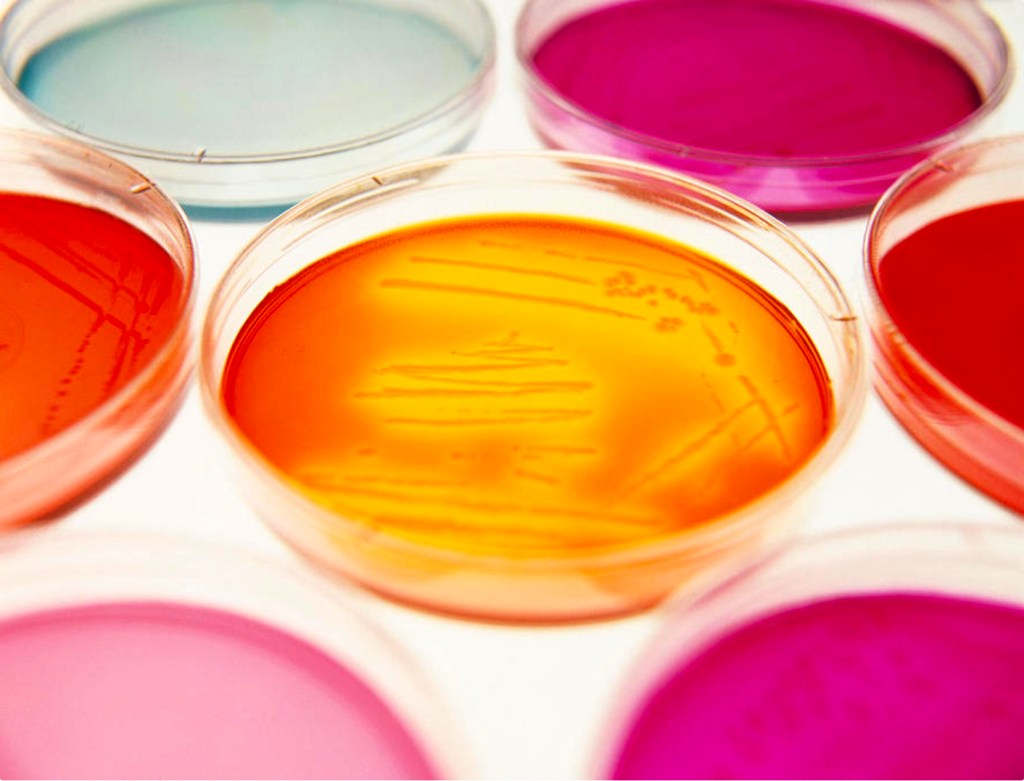

Humans did not get sick in the way we understand before civilization. So where are all of these diseases coming from?
VIRUSES: Animal Domestication Caused The Coronavirus
There have been three waves of infectious diseases in human history. But they have all occurred in just the last 10,000 years since the agricultural revolution. Civilization causes epidemic diseases.
By its nature, civilization is an ideal petri dish to create and spread viruses: Billions of highly mobile people and animals crowded together.
- Cities > Dense human population
- Transportation > Planes, trains, ships and automobiles.
Wave 1. Epidemic Diseases: Animal Domestication
Civilization causes epidemic diseases. The first wave started when we brought animals into the barn yard. They gave us their diseases.[1][2] The problem is not animals; the problem is what civilization does to animals: domestication.
- Measles > Cows and Sheep
- Smallpox > Camels
- Whooping Cough > Pigs
- Typhoid > Chickens
- Leprosy > Water Buffalo
- Flu > Ducks
- Common Cold > Horses.
Wave 2. Diseases of Civilization: Industrial Revolution
The second wave began with the industrial revolution when our unnatural domesticated plant and animal diet started to catch up to us.
- Heart Disease > Poor Civilized Diet
- Obesity > Poor Civilized Diet
- Diabetes > Poor Civilized Diet
- Cancer > Industrial Chemicals, Smoking, Unrestrained Greed.
Wave 3. Emerging Infectious Diseases: Since 1975
In my lifetime the unimaginable has become common place: the era of Soylent Green, factory farming, and bio-engineering.
- Lime Disease, SARS, MERS, Bird Flu > Factory Farming. Exploding meat and dairy demand, even loss of forests and dense human population from cities to suburbia.
- HIV > Chimpanzee, Humans cannibalizing primates for food.
- Coronavirus COVID-19 > Wild bushmeat markets. As highly contagious as Covid-19 is to humans, it should have spread to humans hundreds or thousands of years ago. Or, possible gain-of-function engineering for rapid spreading in government biosafety level 4 (BSL-4) laboratories.[3] Unknown.
FEAR: Beware of The Control System
The Control System will stop at nothing to keep control. A mind disease fuels the fear that maintains civilization. Fear controls the masses. Without it, civilization cannot exist because the system’s people will rebel against any inequity and slavery thrust upon them.
- Brutality: War, police, prison, arm sales, shoot civilians.
- Inequity: Top 1–2 percent owns as much as the bottom 99 percent. If citizens were as wealthy as elites, they would have the same power.
- Slavery: No free food, land, or shelter. The Control System keeps the masses enslaved by keeping us busy working 9-5 jobs to pay for our food, land and shelter. Prior to civilization, all of these were free.
- Incompetence: Incompetent government represents the corporations and is enabled through media mis-information. Another reason why competent and politically seasoned candidates like Bernie Sanders, Elizabeth Warren and Dennis Kucinich are kept at a distance from becoming president.
Wealthy Care for Two Things: Wealth and No Riots
Two charts from March 26, 2020 show the reality of wealth inequality during this crisis. Buoyed by a 2 trillion dollar plundering of the U.S. treasury, left chart, the wealthy bought cheap stocks. The chart on the right shows an explosion of 3.3 million unemployment claims last week. At the absolute worst of the Great Recession we were losing 800,000 jobs per month. This is at least an order of magnitude worse.[4][5]
Look at these charts. The wealthy profit billions during the largest job loss in American history.
Nothing has changed since the Romans publicly nailed dissenters to crosses, distracted the masses with games and quelled discontent with free grain. Today we have endless media, subsidized poison-food and attack drones. As long as we continue to vote for greedy, compassionless, egomaniacs we will get more of the same.
Fear Divides and Controls Us
We are most afraid of uncertainty. Give humans certainty and we start to cope. Pickup the morning paper and the Coronavirus maps look like an alien invasion. Here is some context: Measles 200 million deaths, smallpox 300–500 million, HIV 25 million. 95 percent of Native Americans died from smallpox There were no Native American plagues to kill the Europeans because there were no domesticated animals. There was no Manifest Destiny. Nearly all Native Americans died, while the European colonials walked away unscathed with no remorse and destroyed the continent.
Flu caused 60,000 deaths in 2018. Coronavirus COVID-19, as of today, 25,000 deaths. This is great suffering born mostly by the poor who lack the wealthy’s health care. Coronavirus deaths may exceed 100,000 in 2020. This is terrible, but not as bad as measles or smallpox.[6] This is not an alien invasion or is it of a virus sort?
Coronavirus Lessons
- Be concerned, but stay calm. Self-educate and be prepared.
- While most of humanity has been numbly moving through life in complete denial of climate change, economical inequities, the blatant negative impacts of the military, industrial and chemical complexes and more, the sudden arrival and acceleration of the Coronavirus is giving us a much needed 5-alarm wake-up call.
As cities across the globe are being forced to shelter-in-place to quell the virus, now is a good time to community-up and take back control of our lives from the control system. Learn permaculture, seed growing, natural building, herbal medicine and create community living on some good land with some good people. Building skills that will lead to bartering is the way of the future.
Civilization Is Toxic
Civilization will be a blink in world history. Until we stop domesticating animals and plants, and over-populating more disease will come. If COVID-19 combined with MERS, a third of human population would die.
One-child families are the only solution to every long-term problem from climate change to sickness and poverty. To create a better world, we have to let go of our choke-hold on the wild. We have to get out of Nature’s way. Stop plowing, cutting, mining, building and populating. If we don’t, nature will do it for us. We just witnessed Nature shutting down the world economy with a flick of her wrist.
Education is The Key
Shaking the civilization addiction is going to be a multi-generational educational effort. The message has to come from somewhere and be amplified. As long as the media, government, churches, etc. preach the past, we will not move forward.
Peace on Earth During These Inward Times
Share these ideas person-to-person. Don’t just read these essays, post links on your social media to essays that resonate with you. Our speech is not free if dissenting messages are hidden by search engines, and mainstream media. You found these ideas, now share them with others!
Chuck Burr is author of Culturequake: The Restoration Revolution. Revised Fourth Edition. 10th Anniversary.

Post Editor, Beth Brown — Beth is a lifestyle writer and former assistant news editor of the Easley Progress. She graduated from Columbia College with a focus on Writing and Public Affairs. She is also a singer/songwriter/musician, yogi, activist and Love Warrior for Mother Earth.
[Image 1] Fear Agent. Volume 2. Image Comics. 2018
[1] YouTube: Dr. Michael Greger on Pandemic Prevention | Infectious Diseases, Aids, Influenza, Coronavirus. March 3, 2013
[2] The Aids Institute. Where did HIV come from?
[3] Wikipedia. Biosafety level.
[4] The Wall Street Journal. Dow Rallies 6.4% After Stimulus Vote. March 26 2020. Caitlin McCabe, Anna Hirtenstein and Chong Koh Ping.
[5] Yahoo News. U.S. Unemployment Claims Soar To Record 3.3 Million As Layoffs Jump. March 26 2020. AP. Christopher Rugaber.
[6] Wikipedia. History of smallpox.